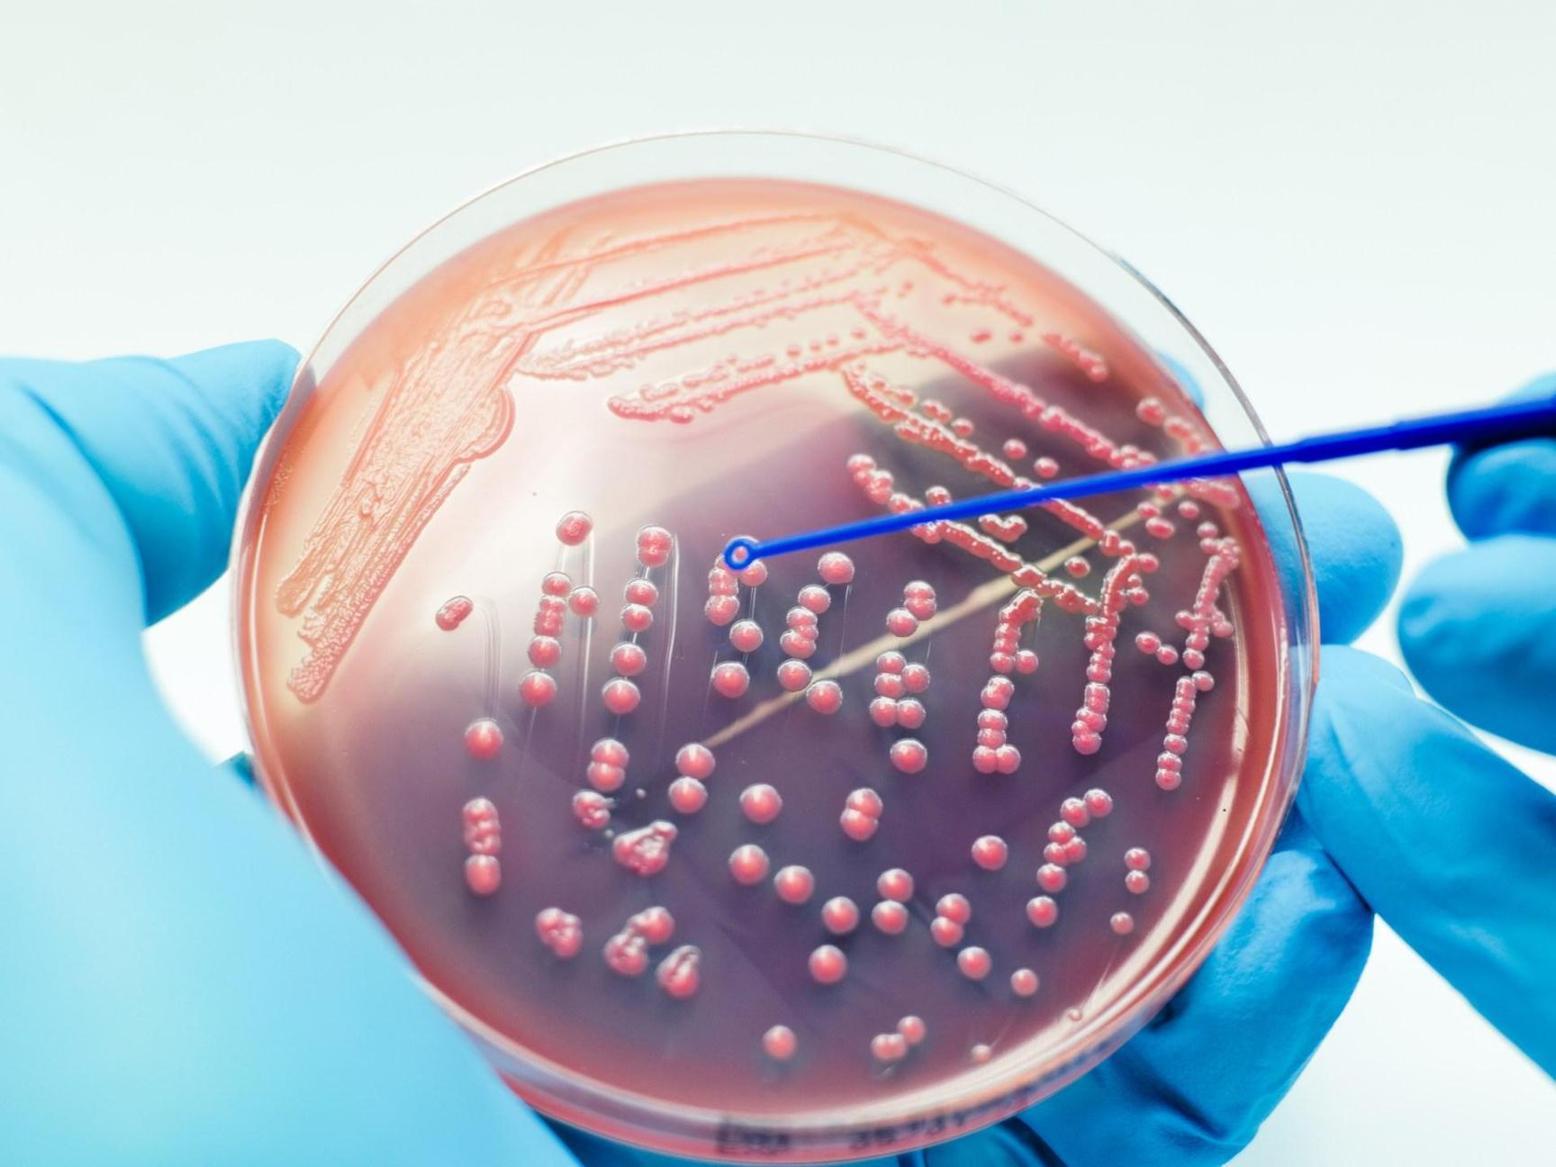
علماء روس يبتكرون مادة تصدر أشعة قاتلة للبكتيريا علماء روس يبتكرون مادة تصدر أشعة قاتلة للبكتيريا

أفريقيا برس – المغرب. ابتكر علماء روس مادة جديدة قادرة على إصدار ضوء فوق بنفسجي لمدة قياسية تصل إلى 40 دقيقة، مما يؤدي إلى قتل ما يصل إلى 99.9% من البكتيريا.
وأثبت الدراسة أنه يمكن استخدام الخصائص القاتلة للبكتيريا لفوسفات الإيتريوم في تطهير مختلف السوائل والأسطح، مما يعني أنها يمكن أن تحل محل مصابيح الأشعة فوق البنفسجية الزئبقية.
وأظهرت العينات التجريبية توهج المركب لمدة تصل إلى قرابة 40 دقيقة، مما اُعتبر رقما قياسيا، مقارنة بنتائج دراسة مماثلة أجريت في الصين حققت توهجا مدته 15 دقيقة فقط.
وقد ابتكر باحثون في جامعة الأورال نماذج من مساحيق فوسفات الإيتريوم والسيراميك بعد شحن مركب بالأشعة السينية، مما أدى إلى توهجه بضوء فوق بنفسجي لفترة طويلة، مطهرا الأسطح.
ويمتلك المركب الجديد مجموعة واسعة من التطبيقات العملية، حيث إن إشعاعه أكثر فعالية بنسبة 70% من الأشعة فوق البنفسجية القريبة والمتوسطة، مما يجعله قادرا على قتل 99.9% من البكتيريا.
وفي سياق متصل، أوضحت يوليا كوزنتسوفا، كبيرة باحثي الدراسة، أنه إذا تم تغطية غرسة بطبقة من هذا المركب فسوف تتطهر بعد تعريضها للأشعة السينية، وسيستمر هذا التأثير إلى ما بعد تركيب الغرسة وتغطيتها بأنسجة الجسم، مما سيؤدي إلى قتل البكتيريا المكونة من البيئة الخارجية، ويقضي على احتمال حدوث التهابات.
يمكنكم متابعة المزيد من أخبار و تحليلات عن المغرب عبر موقع أفريقيا برس